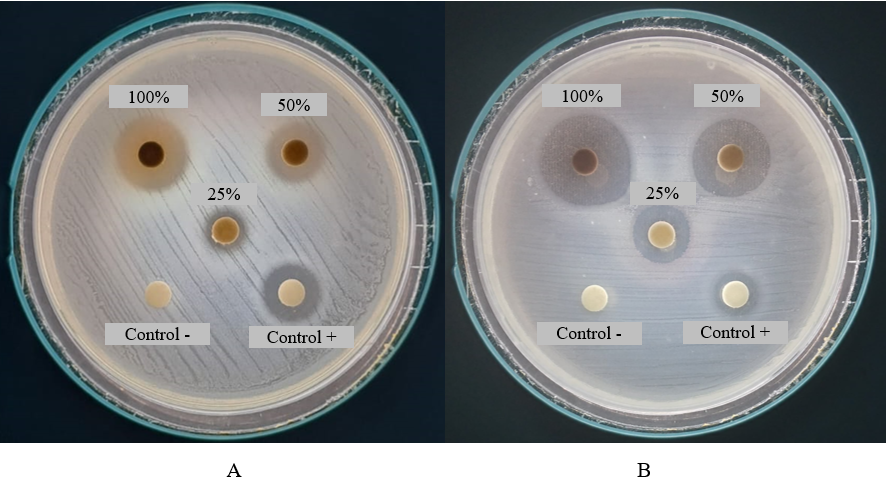

Trends
Sci.
2025; 22(7): 10076
Optimization of Ultrasound-Assisted Extraction of Anthocyanin from Erythrina crista-galli Flowers
Muhammad Habibul Ikhsan1, Abd. Wahid Rizaldi Akili1, Ari Hardianto1,
Jalifah Latip2 and Tati Herlina1,*
1Department of Chemistry, Faculty of Mathematics and Natural Science, Universitas Padjadjaran,
Sumedang, Indonesia
2Department of Chemical Sciences, Faculty of Science and Technology, Universiti Kebangsaan Malaysia,
Selangor, Malaysia
(*Corresponding author’s e-mail: [email protected])
Received: 3 March 2025, Revised: 10 March 2025, Accepted: 17 March 2025, Published: 20 May 2025
Abstract
Anthocyanins are hydrophilic plant pigments from the flavonoid group that offer health benefits. Erythrina crista-galli is one such anthocyanin-containing plant. The ultrasound-assisted extraction (UAE) technique enhances anthocyanin extraction efficiency while reducing solvent use (e.g. ethanol or methanol) and extraction time compared to conventional methods. The effectiveness of UAE for anthocyanin extraction depends on factors such as temperature, solvent concentration, and solid-liquid ratio. This study aims to optimize the extraction of anthocyanins from E. crista-galli using UAE with RSM. The optimized UAE conditions were obtained using 68.71 % ethanol acidified with 1 % citric acid, an extraction time of 30 min, a temperature of 48.15 °C, and a solid-liquid ratio of 0.0435 g/mL. LC-MS/MS-based metabolite profiling identified five anthocyanins in E. crista-galli flowers, namely cyanidin-3-glucoside, cyanidin-3,5-diglucoside, pelargonidin 3,5-diglucoside, pelargonidin 3-glucoside, and pelargonidin-3-sambubioside. The in vitro antioxidant assay showed that E. crista-galli extract exhibited an IC₅₀ value 380.44 ± 4.13 ppm. Additionally, the extract demonstrated significant antibacterial activity against E. coli and S. typhimurium.
Keywords: Erythrina crista-galli, Anthocyanins, Ultrasound-assisted extraction, Response surface methodology, Green extraction
Introduction
Anthocyanins are water-soluble pigments located in the vacuoles of plants. They belong to the flavonoid category, which is accountable for the vibrant colors found in many plant structures, such as fruits, flowers, leaves, stems, tubers, and rhizomes [1]. Researchers recognize anthocyanins for their antioxidant properties, thereby providing antioxidative advantages. Studies have shown that these chemicals can neutralize free radicals and reduce oxidative stress, which is associated with the onset of chronic diseases, including cardiovascular diseases, diabetes, and cancer [2].
Anthocyanins are often used as food colorants due to their excellent benefits. The adverse health effects of
synthetic food coloring prompt this action. Anthocyanins not only serve as food colorants but also possess potential antibacterial properties, which can contribute to preserving food quality [3]. Anthocyanins have been shown to exert their antibacterial activity through various mechanisms, such as inducing damage to bacterial cell damage, destroying the structural integrity of the wall, membrane, and intracellular matrix, inhibiting extracellular microbial enzymes, and antibiofilm activity, as well as affecting microbial metabolism and growth [4].
Erythrina crista-galli, also known as cockspur coral tree, is a species of flowering plant with red petals that indicate the presence of anthocyanins. Research shows that the flowers of E. crista-galli contain cyanidin-3-sophoroside as its main color pigment [5]. Anthocyanins can be extracted from nature using extraction techniques with organic solvents. This extraction process can be influenced by various factors, such as the chemical and physical characteristics of anthocyanins, the extraction method used, particle size, and extraction conditions. Optimizing these influential factors can increase the efficiency and total yield of anthocyanins, as well as the stability and bioactivity of anthocyanins [6].
In recent years, green extraction has gained prominence as a key area of research in extraction technology, focusing on the development of environmentally friendly solvent extraction methods. These techniques aim to reduce resource consumption, minimize energy waste, mitigate environmental impact, and enhance extraction efficiency. One of the widely used green chemistry extraction techniques today is Ultrasound-Assisted Extraction (UAE) [7]. Many studies show that the UAE method is very effective in extracting anthocyanins from various natural sources [8]. Ultrasonic radiation and its mechanical effects on the plant matrix cause cavitation that enhances the transfer of active compounds from the sample to the solvent, thereby efficiently extracting the desired active compounds from natural sources [9]. This method uses less solvent and much faster extraction time. Optimizing the parameters that affect the extraction process is necessary to increase the anthocyanin yield using the UAE method. Factors that need to be optimized include temperature, time, solvent composition, pH, and solid-liquid ratio [7].
Response Surface Methodology (RSM) is a mathematical and statistical technique used widely in various fields, including the extraction of bioactive compounds from natural sources. RSM can facilitate process modeling and optimization by analyzing the relationship between several independent variables and their corresponding responses. According to numerous studies, RSM method is an effective approach for identifying and optimizing the factors that influence the extraction of active compounds from natural sources. RSM is a useful way to find the best solvent type, extraction time, temperature, and solid-liquid ratio for getting back bioactive compounds like antioxidants, anthocyanins, and polyphenols [10].
Numerous studies have shown that anthocyanin-rich extracts exhibit remarkable antioxidant properties. Specifically, pomegranate extracts, which are abundant in anthocyanins, demonstrate excellent antioxidant activity, making them a promising natural source of antioxidants [11]. Antioxidant activity assay was conducted to determine the effectiveness of E. crista-galli flower extract, which contains anthocyanins as antioxidants. Antioxidant activity can be quantified by various methodologies, one of which is the 1,1-diphenyl-2-picrylhydrazyl (DPPH) radical assay. When DPPH radicals come into contact with an antioxidant compound, they are reduced, resulting in a color change from purple to yellow and a simultaneous decrease in absorbance at 517 nm [12]. The antioxidant efficacy of a compound is classified based on its IC50 value, which represents the concentration of an antioxidant required to reduce the DPPH radical content by 50 %.
Bacteria are the most common biological agents responsible for food contamination, often leading to illnesses such as bacterial gastroenteritis. This condition, caused exclusively by bacterial infections, presents non-specific symptoms including nausea, vomiting, fever, diarrhea, abdominal cramping, and pain [13]. In the search for alternative treatments for bacterial infections, anthocyanins have gained attention in numerous studies due to their extensive health benefits and therapeutic potential. Several studies have demonstrated that anthocyanin-rich extracts effectively inhibit the growth of various bacterial strains, including Staphylococcus aureus, Enterococcus faecalis, Escherichia coli, and Pseudomonas aeruginosa [3].
Up until now, no research has optimized the extraction process of anthocyanins from E. crista-galli flowers using a combination of UAE and RSM. The main objective of this study is to determine the optimum conditions for anthocyanin extraction from E. crista-galli flowers using UAE method combined with RSM. Furthermore, the extracted anthocyanins will be evaluated for their bioactivities, including antioxidant and antibacterial properties, to explore their potential applications.
Materials and methods
Materials
In the optimization process of anthocyanin extraction from E. crista-galli L. flowers, fresh flowers were collected from Bandung, West Java, Indonesia. These plant materials have been determined at the Laboratory of Agricultural Production Technology & Services, Agricultural Cultivation Department, Faculty of Agriculture, Universitas Padjajdaran, under voucher specimen number 1020.
Chemicals
All the chemical compounds required for the biochemical analysis and extraction process like ethanol, sodium acetate (CH3COONa), potassium chloride (KCl), ethanol (96 %), citric acid monohydrate (99 % purity) were obtained from Sigma-Aldrich, Germany.
Ultrasound-assisted extraction process
Antocyanins from E. crista-galli flowers were extracted using ultrasonic processor (Model LC 30 H), frequency of 20 kHz and an ultrasonic input power of 500 W for total anthocyanins Ultrasonic treatment was carried out in a 500 mL water bath.
Experimental design and statistical analysis
Total anthocyanin contents (TAC)
The total anthocyanin content (TAC) was quantified utilizing the pH-differential technique [14]. The buffer system comprised 2 solutions: A potassium chloride buffer (0.025 M KCl) with a pH of 1.0 and a sodium acetate buffer (0.4 M CH3COONa) with a pH of 4.5. The pH of the 2 buffer solutions was calibrated to 1.0 and 4.5, respectively. A 0.025 mL aliquot of the sample was transferred to a 5 mL volumetric flask and diluted to the final volume with CH3COONa buffer at pH 4.5. An additional 0.025 mL of the sample was transferred into a 5 mL volumetric flask and diluted to the final volume with KCl buffer at pH 1. A 3 mL sample was placed into a 3.0 mL cuvette and analyzed with a UV-visible visible spectrophotometer Thermo Scientific G10S (Thermo Fisher Scientific, Madison, WI, USA) at wavelengths of 520 nm and 700 nm, respectively. This study quantified the total anthocyanin content in terms of cyanidin 3-O-glucoside equivalents. The overall anthocyanin concentration was determined using the subsequent equation:
A represents the difference between (A520 - A700) at pH 1.0 and (A520 - A700) at pH 4.5; MW indicates the molecular weight (449.2 g/mol) of cyanidin-3-glucoside; DF means the dilution factor; Vt indicates the total volume (mL); E refers to the molar extinction coefficient (26.900) of cyanidin-3-glucoside; l is the path length (1 cm); and M represents the weight of E. crista-galli flowers.
Fractional factorial design
Fractional Factorial Design is a method that facilitates the efficient investigation of the impacts of several factors on a specific response. These approaches facilitate the evaluation of numerous aspects with a limited number of experimental circumstances. This methodology has been extremely useful in research focusing on process improvement and the extraction of certain chemicals. Researchers can gain significant insights into the correlations among variables with fewer experimental trials. In this experiment, the R package FrF2 library for design and analysis of experiments with 2-level factors [15]. In this selection parameters, ethanol concentrations of 40 and 80 %, each acidified with 1 % citric acid, were utilized as solvents. Extraction temperatures were set at 25 and 50 °C, with durations of 10 and 30 min. Solid-liquid ratios of 1.25 and 2.5 g of sample per 20 mL of solvent were used, and the extraction procedure was performed once and twice.
Curvature check
After attaining the experimental results using the fractional factorial design, we applied the curvature check method to verify the results. We employ this method to ascertain the presence of a non-linear relationship between the factor (X) and the response (Y). A curved relationship may render the factorial design inappropriate, as the results could be deceptive. A p-value, in statistical hypothesis testing, quantifies the degree of evidence against the null hypothesis.
The Central Composite Design (CCD) was applied as an optimization technique inside the RSM framework to examine the effects of independent factors on the sorption process. This study utilized CCD to determine the ideal process factors for anthocyanin extraction from E. crista-galli using the UAE method. CCD is a popular experimental design applied in Response Surface Methodology (RSM) to construct second-order models. CCD consists of factorial points, axial points, and central points, thereby facilitating an extensive analysis of linear and quadratic effects [16]. Through the use of CCD, researchers are able to optimize processes, predict responses, and effectively study the influence of different variables on results.
RSM data analysis was conducted using RSM package in R software [17]. The optimization experiments followed a CCD and consisted of 22 runs, including 8 central points and 14 non-central points. In these experiments, 3 factors (temperature, solvent concentration, and solid-liquid ratio) were selected as independent variables, while total anthocyanin content (TAC) was measured as the dependent variable. The relationship between the independent and dependent variables was analyzed using the least-squares multiple regression approach. A second-order polynomial equation was derived from the experimental data through multiple regression analysis, as shown in the following equation.
Where Y is the response variable; β0 is the intercept; βi, βii and βij are are the regression coefficients, Xi, Xj are the independent variables or factors, n is the number of factors and ε is error
The 2,2’-Diphenyl-1- Picryl-Hydrazyl (DPPH) Assay
The extract's scavenging ability was evaluated using a modified DPPH radical scavenging assay. A stock solution was prepared at a concentration of 10,000 ppm in methanol, which was then diluted into various concentrations. The diluted solutions were reacted with DPPH radicals and incubated at room temperature for 30 min. Following incubation, the absorbance of each sample was measured at 517 nm using a UV-Vis spectrophotometer to evaluate the extract's antioxidant activity.
Results and discussion
To optimize the extraction method, a systematic selection of parameters is necessary to increase the total yield of target compounds. Previous studies have developed ultrasound-assisted extraction to enhance the anthocyanin yield from natural sources. Key factors such as solvent concentration, extraction time, temperature, and the solid-liquid ratio significantly influence anthocyanin yield. These studies indicate that solvent concentration, extraction time, temperature, solid-liquid ratio, and number of extractions are critical factors in maximizing total anthocyanin yield [18].
Fractional factorial design
The total anthocyanin content was used as the dependent variable in the extraction process. A fractional factorial design was applied in this experiment, involving 5 parameters, each tested at 2 levels. These parameters included solvent concentration, temperature, extraction time, and solid-liquid ratio. The 2-Level Factorial Fractional Design was employed to identify the parameters influencing the extraction yield of anthocyanins from E. crista-galli flowers. This parameter selection process involved 5 factors, each tested at 2 levels: Extraction time, temperature, solvent concentration, solid-liquid ratio, and the number of extractions. By optimizing these extraction conditions, the process aims to maximize extraction efficiency.
Table S(1) presents the experimental design and results of parameter selection based on the total anthocyanin content extracted from E.crista-galli flowers. It is well-known that high values of ethanol in the solvents increase the extraction of bioactive compounds from plant materials. However, these studies pointed out the importance of the amount of ethanol in the solvent mixture in the selective extractions of individual anthocyanins [18].
The results of parameter selection are presented in Figure 1 as Main Effect Plots. The figure highlights 3 parameters that significantly influence the total anthocyanin content. Among these, temperature is shown to affect extraction efficiency, with 50 °C yielding higher anthocyanin content compared to 25 °C. This outcome is attributed to the increased kinetic energy of solvent molecules at higher temperatures, which accelerates the diffusion rate of compounds and enhances the efficiency of the extraction process [18].
Similarly,
a higher ethanol concentration as a solvent results in improved
extraction yields, as increased ethanol concentration enhances the
recovery of bioactive compounds from plant materials [18].
In contrast, the solid-liquid ratio shows an inverse relationship
with extraction efficiency, where a lower solid-liquid ratio leads
to higher extraction yields. This observation aligns with the theory
that increasing the solvent volume relative to the sample weight
reduces the mixture's viscosity, thereby intensifying cavitation
effects and improving extraction effectiveness. On the other hand, a
higher solid-liquid ratio increases viscosity, which can potentially
hinder cavitation induced by ultrasonic waves [7].
Although the figure suggests that nearly all selected parameters
influence the extraction of anthocyanins from E.
crista-galli
flowers, the results from the Analysis of Variance (ANOVA) indicate
that only temperature (p-value
3.19 10−4),
solvent concentration (p-value
7.11
10−4),
solvent concentration (p-value
7.11 10−4),
and solid-liquid ratio (p-value
1.15
10−4),
and solid-liquid ratio (p-value
1.15 10−2)
have a statistically significant impact on anthocyanin extraction.
10−2)
have a statistically significant impact on anthocyanin extraction.
Although nearly all of the selected parameters in the Figure 1 show some impact on the extraction of anthocyanins from E. crista-galli flowers, the results from the Analysis of Variance (ANOVA) indicate that only temperature, solvent concentration, and solid-liquid ratio have a statistically significant effect on anthocyanin extraction, as evidenced by the p-value being less than 0.05. Following this parameter selection, the optimization process will proceed using CCD approach, with the selected parameters serving as the basis for further testing.
Curvature check
After the parameter selection process, the next step is to conduct a curvature check test to assess whether there is a non-linear relationship in the constructed model. This test generates a p-value, which is used to determine whether the null hypothesis (H₀) can be accepted or rejected. In this experiment, the null hypothesis states that there is no non-linear relationship between the factors and the response, while the alternative hypothesis (H₁) suggests the presence of such a relationship. The null hypothesis is rejected if the p-value is < 0.05, and accepted if the p-value is > 0.05. The curvature check experiment was conducted with 13 trials, including 5 central points. This experiment focused on the 3 parameters most influential in the anthocyanin extraction process from E. crista-galli flowers. The parameters used were temperature, ethanol concentration, and solid-liquid ratio. The results of the curvature check experiment are presented in Table 1.
Table 1 The Curvature check for optimizing the total anthocyanin concentration from E. crista-galli flowers extract. The result of the parameter selection experiment is in the TAC column.
No |
Parameters |
TAC (mg/g) |
||
Temperature (°C) |
Solvent concentration (%) |
Solid-liquid ratio (g/20 mL) |
||
1 |
46 |
41 |
1.25 |
2.2359 |
2 |
46 |
41 |
1.25 |
2.2363 |
3 |
45 |
39 |
1.20 |
1.8266 |
4 |
47 |
43 |
1.20 |
2.2983 |
5 |
47 |
43 |
1.30 |
2.2235 |
6 |
47 |
39 |
1.20 |
2.2942 |
7 |
46 |
41 |
1.25 |
2.2396 |
8 |
47 |
39 |
1.30 |
2.0722 |
9 |
45 |
43 |
1.20 |
2.2251 |
10 |
45 |
43 |
1.30 |
2.4630 |
11 |
45 |
39 |
1.30 |
2.2434 |
12 |
46 |
41 |
1.25 |
2.2390 |
13 |
46 |
41 |
1.25 |
|
Based on the ANOVA analysis, the p-value for the curvature check test was found < 0.05. With this p-value, the null hypothesis stating that there is no non-linear relationship between the factors and the response is rejected. This indicates the presence of a non-linear relationship between the factors and the response, thus the alternative hypothesis is accepted. From these findings, it can be concluded that using CCD is the appropriate approach for optimizing the anthocyanin extraction process from E. crista-galli flowers, as CCD allows for modeling both linear and non-linear relationships. By integrating second-order effects through CCD, the model’s accuracy is expected to improve, enabling the identification of optimal conditions in the extraction process with greater reliability.
Central composite design
The optimization of anthocyanin extraction from E. crista-galli flower extract was carried out using the CCD-RSM modeling approach. CCD was applied to optimize the influence of 3 parameters selected based on the results of the previous parameter selection, namely solvent concentration, extraction temperature, and solid-liquid ratio. Each combination of parameters was evaluated based on the total anthocyanin content. Table 2 presents the experimental design and optimization results using the CCD modeling approach.
Table 2 CCD for the UAE of total anthocyanin concentration from E. crista-galli flowers extract. The result of the parameter selection experiment is in the TAC column.
No |
Parameters |
TAC (mg/g) |
|||
Run |
Temperature (°C) |
Solvent concentration (%) |
Solid-liquid ratio (g/20 mL) |
||
1 |
1 |
47 |
43 |
1.2 |
2.2983 |
2 |
2 |
45 |
39 |
1.3 |
2.2434 |
3 |
3 |
45 |
43 |
1.3 |
2.4630 |
4 |
4 |
47 |
39 |
1.2 |
2.2942 |
5 |
5 |
47 |
39 |
1.3 |
2.0722 |
6 |
6 |
46 |
41 |
1.25 |
2.2396 |
7 |
7 |
45 |
43 |
1.2 |
2.2251 |
8 |
8 |
47 |
43 |
1.3 |
2.2235 |
9 |
9 |
45 |
39 |
1.2 |
1.8266 |
10 |
10 |
46 |
41 |
1.25 |
2.1843 |
11 |
11 |
46 |
41 |
1.25 |
2.2103 |
12 |
12 |
46 |
41 |
1.25 |
2.2390 |
13 |
1 |
47.5 |
41 |
1.25 |
2.1481 |
14 |
2 |
46 |
41 |
1.25 |
2.2349 |
15 |
3 |
46 |
41 |
1.25 |
2.2391 |
16 |
4 |
46 |
41 |
1.25 |
2.2635 |
17 |
5 |
46 |
41 |
1.16 |
2.0940 |
18 |
6 |
44.5 |
41 |
1.25 |
2.1359 |
19 |
7 |
46 |
41 |
1.33 |
2.2396 |
20 |
8 |
46 |
41 |
1.25 |
2.2845 |
21 |
9 |
46 |
37.64 |
1.25 |
2.0477 |
22 |
10 |
46 |
44.36 |
1.25 |
|
The influence of each parameter tested on the TAC was further analyzed using ANOVA. In this optimization process, a second-order model was employed to illustrate how the tested variables are related to the TAC value. This model takes into account linear effects (FO), 2-way interactions (TWI), and quadratic effects (PQ). The data from the ANOVA results can be seen in Table 3. The FO effect indicates that each independent variable has a direct impact on the response. The analysis revealed that the FO effect has a Sum of Squares (Sum Sq) value of 0.1598 and an F-value of 26.4673, indicating that the FO effect significantly contributes to and influences the anthocyanin extraction results. This is further supported by the significant p-value (p-value < 0.05). Based on the results, it is evident that the FO effect plays a significant role in the optimization of anthocyanin extraction from E. crista-galli flowers
In
addition to the FO effect, TWI effect also showed a significant
influence on the optimization process of anthocyanin extraction from
E.
crista-galli
flowers. This is demonstrated by the p-value
of 2.774 10−⁵
(< 0.05), indicating that the interactions between the factors
have a significant impact on the extraction results. This highlights
the importance of factor interactions in influencing the response,
where the combination of certain factors can affect and enhance the
extraction efficiency. On the other hand, PQ effect showed a p-value
of 0.1085 (> 0.05), indicating that the quadratic effect is not
significant in this model. This suggests that there is no
significant non-linear relationship between the variables
influencing the response.
10−⁵
(< 0.05), indicating that the interactions between the factors
have a significant impact on the extraction results. This highlights
the importance of factor interactions in influencing the response,
where the combination of certain factors can affect and enhance the
extraction efficiency. On the other hand, PQ effect showed a p-value
of 0.1085 (> 0.05), indicating that the quadratic effect is not
significant in this model. This suggests that there is no
significant non-linear relationship between the variables
influencing the response.
Table 3 ANOVA for the total anthocyanins content.
Response |
DF |
Sum Sq |
Mean sq |
F-Value |
p-value |
FO (X1, X2, X3) |
3 |
0.1598 |
0.0533 |
26.4673 |
1.415 |
TWI (X1, X2, X3) |
3 |
0.1400 |
0.0467 |
23.1976 |
2.774 |
PQ (X1, X2, X3) |
3 |
0.0151 |
0.0050 |
2.5074 |
0.1085 |
Residuals |
12 |
0.0242 |
0.0020 |
|
|
Lack of Fit |
5 |
0.0177 |
0.0035 |
3.8271 |
0.05443 |
Pure error |
7 |
0.0065 |
0.0009 |
|
|
R2 |
0.9288 |
Adjusted R2 |
0.8754 |
|
The test results indicate that this model effectively explains the response variation, as demonstrated by the high R2 value and the non-significant lack of fit, which underscore the model’s proficiency in predicting the response. The multiple R2 value of 0.9288 shows that the model accounts for approximately 92.88 % of the response variation, indicating strong explanatory power. Additionally, the adjusted R2 value of 0.8754, which adjusts for the number of predictors, further reinforces the model’s accuracy. This high R2 value suggests that the second-order model provides an excellent fit to the data, demonstrating the effectiveness of the independent variables in explaining response variation. Furthermore, the non-significant lack of fit (p-value > 0.05) implies that the model is appropriate, with no strong evidence of misfit. This supports the reliability of the second-order approach in capturing the relationship between the independent variables and the response. Overall, the second-order model is effective for identifying optimal conditions in the extraction process, as it captures complex relationships between variables that a simple linear model cannot describe.
Figure 2 illustrates how to evaluate the results of the CCD method using 3-dimensional (3D) surface plots and contour plots (2D representations). The 3D surface plots visually depict the interactions among the test variables and their impact on the response, while the contour plots show a 2-dimensional perspective of these relationships. We created the 3D surface plots to visually display the experiment results and illustrate the relationship models between 2 independent factors and their impact on the TAC.

Figure 2 Response surface for the effect of process conditions on the resulting anthocyanin extract at (a) temperature interaction with solvent concentration, (b) temperature with solid-liquid ratio, and (c) solvent concentration with solid-liquid ratio.
TAC increases with temperature up to an optimal point of 48.15 °C, after which it declines due to the degradation of anthocyanins at higher temperatures. This trend highlights a key balance in the extraction process, where temperature initially enhances the release of anthocyanins from the matrix but eventually causes their breakdown when the temperature surpasses the stability threshold. The observed trend is consistent with established theories, which demonstrated that prolonged exposure to elevated temperatures and extended extraction times accelerate the degradation of anthocyanins, reducing their concentration [19]. Additionally, TAC showed a positive correlation with the solid-liquid ratio, suggesting that efficient solvent penetration and extraction are critical to maximizing anthocyanin yield. The solid-liquid ratio affects the solvent’s ability to diffuse into the plant matrix, with higher ratios generally increasing anthocyanin recovery. After reaching an equilibrium phase, further increases in the solvent amount have no significant impact on yield. Excess solvent can actually reduce recovery efficiency due to uneven solvent distribution and microwave exposure, as it requires more time and energy [20].
Another critical factor was the interaction between solvent concentration and the solid-liquid ratio. In the plot depicting the relationship between solvent concentration and solid-liquid ratio at a fixed temperature, a significant positive influence on TAC is observed with increasing solvent concentration, particularly at lower solid-liquid ratios. The data indicated an optimal condition at a solid-liquid ratio of 0.043 g/mL. Increasing this ratio resulted in a decrease in anthocyanin concentration, likely due to the saturation of the solvent, which reduced its capacity to extract additional anthocyanins from the sample [21]. However, the increase in TAC diminishes at higher solid-liquid ratios, suggesting that extraction capacity has reached a maximum at a specific solvent ratio.
Furthermore, we examined the relationship between the solid-liquid ratio and solvent concentration. The experimental results demonstrated that increasing the solvent concentration correlated with a higher anthocyanin yield, reaching an optimum at an ethanol concentration of 68.71 %. This observation underscores the importance of precisely calibrating solvent concentration to optimize anthocyanin extraction. The decline in anthocyanin content at higher ethanol concentrations can be attributed to multiple factors. First, the polarity of the solvent plays a crucial role; increasing ethanol concentration reduces the solvent’s polarity, which may affect the solubility of anthocyanins [22]. Additionally, increasing ethanol content may reduce water-soluble components in the solvent mixture, which can hinder anthocyanin solubility, as anthocyanins are widely recognized as water-soluble pigments [20]. This analysis demonstrates that the interactions among temperature, solvent concentration, and solid-liquid ratio significantly impact the optimization of anthocyanin extraction. The study underscores the importance of precise control over extraction variables in the UAE method and highlights the effectiveness of the RSM approach in modeling variable interactions and identifying strategies to enhance anthocyanin extraction efficiency.
The optimal conditions for anthocyanin extraction from E. crista-galli flowers using the UAE method were achieved with 68.71 % ethanol acidified with 1 % citric acid as the solvent. The extraction was conducted for 30 min at 48.15 °C with a solid-liquid ratio of 0.8699 g of sample per 20 mL of solvent. Total anthocyanin content of 2.7601 mg/g was achieved based on the predicted optimization parameters. This predicted outcome was subsequently compared with the empirically obtained value using a t-test. The data indicate a p-value of 0.3713, which is greater than 0.05, suggesting that the result is not statistically significant. This indicates inadequate evidence to dismiss the null hypothesis, which asserts that the mean of the observed data (2.8699 mg/g) does not significantly deviate from the expected mean (2.76015 mg/g). The 95 % confidence interval corroborates this finding, as the anticipated TAC value of 2.76015 mg/g resides within this range, reinforcing the notion that there is no significant difference between the sample mean and the expected mean. The empirically calculated sample mean of 2.8699 mg/g closely aligns with the anticipated mean of 2.76015 mg/g, and the T-test verifies that this slight variance is not statistically significant.
Identification of anthocyanins from extract by LC-MS/MS
Based on LC-MS/MS profiling, E. crista-galli extract contains several peaks of anthocyanin compounds. These peaks were analyzed and compared with previously published data. Based on the LC-MS/MS analysis, it is known that the E. crista-galli flower extract has 5 anthocyanin compounds with a basic structure of cyanidin and pelargonidin anthocyanidins. Chromatogram from the LC-MS/MS analysis is given in the Figure 3. The structure of anthocyanins tentatively identified in E. crista-galli flower extract using LC-MS/MS is given in the Table 4. The LC-MS/MS analysis revealed the presence of five anthocyanins in the extract: cyanidin 3,5-diglucoside, cyanidin 3-glucoside, pelargonidin 3-glucoside, pelargonidin 3,5-diglucoside, and pelargonidin 3-sambubioside.

Figure 3 Chromatogram of ethanol extract E. crista-galli obtained from LC-MS/MS analysis.
Table 4 List of structure anthocyanins tentatively identified in E. crista-galli flower extract using LC-MS/MS.
Compound |
RT (min) |
m/z |
Molecular Formula |
Mass error (ppm) |
Source from nature |
Reference |
Cyanidin-3,5-diglucoside |
4.270 |
611.1602 |
C27H31O16+ |
1.6 |
E. suberosa Rox Punica granatum L
|
[11,23] |
Cyanidin 3-glucoside |
4.395 |
449.1081 |
C21H21O11+ |
0.7 |
E. corallodendron E. falcata, E. dominguezii, E. herbacea Punica granatum L
|
[11,23] |
Pelargonidin 3-glucoside |
4.621 |
433.1129 |
C21H21O10+ |
1.8 |
E. crista-galli Actinidia arguta |
[23,24]
|
Pelargonidin 3,5-diglucoside |
4.642 |
595.1663 |
C27H31O15+ |
0 |
Punica granatum L |
[11,25] |
Pelargonidin 3-sambubioside |
4.923 |
565.1551 |
C26H29O14+ |
1.1 |
Aeschynanthus pulcher
|
Cyanidin-3,5-diglucoside was identified at a retention time of 4.27 min with m/z 611.1602 (C27H31O16+, mass error = 1.6 ppm). MS/MS analysis showed a fragment at m/z 287.0556, corresponding to the loss of a sugar group. This compound has previously been isolated from E. suberosa Rox [23]. Cyanidin 3-glucoside was identified at a retention time of 4.395 min with m/z 449.1081 (C21H21O11+, mass error = 0.7 ppm). MS/MS analysis also revealed a fragment at m/z 287.0555 due to the loss of a sugar group. This anthocyanin has been identified in E. corallodendron, E. falcata, E. dominguezii, and E. herbacea [23]. Cyanidin 3-glucoside has demonstrated antioxidant activity and also exhibits anti-inflammatory effects, reducing intracellular reactive oxygen species and DNA damage [27]. The subsequent anthocyanin identified was pelargonidin-3-glucoside, which was observed at a retention time of 4.621 min with m/z 433.1129 (C21H21O10+, mass error = 1.8 ppm). LC-MS/MS analysis revealed a fragment at m/z 271.0611, indicating the loss of a sugar moiety. This compound has been previously reported in E. crista-galli and Actinidia arguta [23,24] . Pelargonidin 3-glucoside exhibits a range of biological activities, such as antioxidant, anti-inflammatory, antihyperglycemic, anti-obesity, antidiabetic, neuroprotective, and anticancer properties [28].
The next compound, pelargonidin-3,5-diglucoside, was detected at a retention time of 4.642 min with m/z 595.1663 (C27H31O15+, mass error = 0 ppm). LC-MS/MS analysis indicated a fragment at m/z 271.0601, which corresponds to the loss of a sugar group. This anthocyanin has been previously identified in Punica granatum [11,25]. Lastly, pelargonidin-3-sambubioside was identified at a retention time of 4.923 min with m/z 565.1551 (C26H29O14+, mass error = 1.1 ppm). The LC-MS/MS analysis showed a fragment at m/z 271.0601, following the loss of a sugar group. This compound was previously identified in Aeschynanthus fulgens and Aeschynanthus pulcher [26]. This study offers a detailed identification and characterization of the anthocyanin profile in the flower extract of E. crista-galli, emphasizing their potential bioactive properties, including antioxidant activity.
Radical DPPH scavenging activity
Antioxidant activity assay was conducted to determine the effectiveness of E. crista-galli flower extract, which contains anthocyanins as antioxidants. Anthocyanins are compounds with antioxidant properties due to their capacity to neutralize free radicals. Typically, anthocyanins neutralize reactive radical species through electron transfer or hydrogen atom donation from their phenolic groups [29]. Antioxidant activity can be quantified by various methodologies, one of which is the 1,1-diphenyl-2-picrylhydrazyl (DPPH) radical assay. The DPPH assay is a widely recognized technique for assessing in vitro antioxidant activity. The deep purple color of the DPPH radical solution is distinctive, with peak absorbance occurring at a wavelength of 517 nm [30]. When DPPH radicals come into contact with an antioxidant compound, they are reduced, resulting in a color change from purple to yellow and a simultaneous decrease in absorbance at 517 nm. The antioxidant efficacy of a compound is classified based on its IC50 value, which represents the concentration of an antioxidant required to reduce the DPPH radical content by 50 %. This value is determined by plotting the percentage of radical scavenging activity against the concentration of the antioxidant. A lower IC50 value indicates stronger antioxidant activity [31].
The antioxidant activity of the extract was evaluated, but the results were unsatisfactory. The extract demonstrated an IC50 value of 380.44 ± 4.13 ppm. Furthermore, the ethanol extract was further subjected to fractionation with different solvent of increasing polarity, i.e., n-hexane, ethyl acetate, and butanol. Among these fractions, the butanol fraction exhibited strong antioxidant activity with IC50 value of 68.78 ± 1.49 ppm. Fractionation is a process that separates mixtures into fractions with different polarities. Butanol, being a more polar solvent compared to n-hexane and ethyl acetate, is capable of extracting polar compounds from ethanolic flower extracts, including anthocyanins [32]. This explains why the antioxidant the butanol fraction exhibited strong antioxidant activity
Antibacterial activity
Numerous studies have explored the potential benefits of anthocyanin extracts as a potential therapy for addressing bacterial contamination in food. Research indicates that anthocyanin-rich extracts derived from natural sources possess antibacterial properties, effectively inhibiting the proliferation of various bacterial strains. These findings highlight their potential as natural antimicrobial agents for applications in health and food industries [3]. Research has shown the antibacterial properties of anthocyanins via multiple methods, such as the destruction of bacterial cells and the suppression of extracellular enzyme activity. Additionally, anthocyanins are recognized for their ability to bind to DNA, potentially obstructing DNA replication, transcription, and expression within bacterial cells, ultimately leading to cell death. Anthocyanins can also weaken bacterial cell walls and membranes, causing protein leakage, disruptions in protein synthesis, and degradation of bacterial proteins. These effects can significantly impair the metabolism and growth of E. coli and other microbes [3].
Figure 4 Inhibition Zone Diameter: Extract anthocyanins from E. crist-galli flowers against (A) (E. coli) and (B) (Salmonella typhimurium) bacteria.
Table 5 Antibacterial activities of anthocyanin extract from E. crista-galli against E. coli and Salmonella Thypimurium.
Extract |
Inhibition zone diameter (mm) |
|
Escherichia coli |
Salmonella Thypimurium |
|
100 % |
15.37 ± 0.36 |
19.42 ± 0.26 |
50 % |
12.24 ± 0.73 |
16.33 ± 0.465 |
25 % |
8.74 ± 0.08 |
12.12 ± 0.45 |
DMSO 2 % (Control Negative) |
6 ± 0 |
6 ± 0 |
Amoxycillin (Control Positive) |
11.78 ± 0.01 |
9.64 ± 0.375 |
The antibacterial activity of anthocyanin extracts from E. crista-galli flowers can be assessed by measuring the diameter of the inhibition zone produced by the extract against bacteria. The inhibition zone diameter is a commonly used method for antibacterial testing, where the area of no bacterial growth around the test disc is measured. A larger inhibition zone diameter indicates greater antibacterial efficacy of the extract against the tested bacteria [33]. The concentration and quantity of anthocyanin extract influence the diameter of the inhibition zone, with increased anthocyanin content directly proportional to the expansion of the inhibition zone. Figure 4 illustrates the inhibition zone diameter of anthocyanin extract from E. crista-galli flowers against E. coli and Salmonella typhimurium. The test results in Table 5 demonstrate the significant antibacterial activity of the anthocyanin extract, categorizing the inhibition zone as strong antibacterial activity. This test also compared the antibacterial activity of E. crista-galli anthocyanin extracts with the positive control, amoxicillin. Amoxicillin is a commonly utilized antibiotic for the treatment of many different bacterial infections and particularly efficient against E. coli strains and Salmonella spp [34]. Based on the results, it was shown that the anthocyanin extract from E. crista-galli flowers exhibited antibacterial properties, as indicated by its large inhibition zone diameter.
Conclusions
Through a series of experiments, we established the ideal conditions for anthocyanin extraction from E. crista-galli flowers using the UAE method. The optimal conditions for extraction are a temperature of 48.15 °C, a solid-to-liquid ratio of 0.043 g/mL, and an ethanol concentration of 68.71 % acidified with 1 % citric acid. Ultrasound technology facilitates a more expedited extraction process, requiring about 30 min, thereby significantly decreasing the time compared to traditional extraction methods. The optimized extract's total anthocyanin content was measured at 2.8699 mg/g. Five anthocyanin compounds were tentatively identified using LC-MS/MS. These are Cyanidin-3,5-diglucoside, Cyanidin 3-glucoside, Pelargonidin 3-glucoside, Pelargonidin 3,5-diglucoside, and Pelargonidin 3-sambubioside. The anthocyanin extract from E. crista-galli flowers exhibited antioxidant activity, with an IC50 value of 380.44 ± 4.13 ppm. Additionally, anthocyanin extract from E. crista-galli flowers demonstrated significant antibacterial activity against E. coli and Salmonella typhimurium.
Acknowledgements
The authors are grateful to the Indonesian Ministry of Research, Technology, and Higher Education for Grant of scholarship for the Masters to Doctoral Program for Superior Scholars (4015/UN6.3.1/PT.00/2024) and the Directorate of Research and Community Engagement Universitas Padjadjaran, Indonesia, for providing support during the research. In addition, the authors are thankful to Universitas Padjadjaran, Indonesia, for providing the required facilities.
References
[1] GCP Goncalves, ALG Rosas, RCD Sousa, TRR Vieira, TCDA Sousa, T Ramires, TFFD Silveira, L Barros, WPD Silva, ARG Dias, EDR Zavareze and AD Meinhart. A green method for anthocyanin extraction from Clitoria ternatea flowers cultivated in southern Brazil: Characterization, in vivo toxicity, and biological activity. Food Chemistry 2024; 435, 137575.
[2] F Zheng, Y Wang, Y Wu, M Zhang, F Li, Y He, L Wen and H Yue. Effect of stabilization malvids anthocyanins on the gut microbiota in mice with oxidative stress. Journal of Food Biochemistry 2021; 45(12), 4892-4902.
[3] EJ Jeyaraj, GCV Gamage, JC Cintrat and WS Choo. Acylated and non-acylated anthocyanins as antibacterial and antibiofilm agents. Discover Food 2023; 3, 21.
[4] H Deng, X Meng, B Xue and L Li. Unveiling the antibacterial potential of anthocyanins – a comprehensive review on this natural plant extract. Taylor & Francis, Oxford, 2024.
[5] T Arita, S Miyazaki, S Teramoto and K Yoshitama. Major anthocyanin biosynthesis in the brilliant crimson petals from Erythrina crista-galli L. Scientia Horticulturae 2014; 168, 272-280.
[6] X Li, F Zhu and Z Zeng. Effects of different extraction methods on antioxidant properties of blueberry anthocyanins. Open Chemistry 2021; 19, 138-148.
[7] L Shen, S Pang, M Zhong, Y Sun, A Qayum, Y Liu, A Rashid, B Xu, Q Liang, H Ma and X Ren. A comprehensive review of ultrasonic assisted extraction (UAE) for bioactive components: Principles, advantages, equipment, and combined technologies. Ultrasonics Sonochemistry 2023; 101, 106646.
[8] Z Kobus, A Pecyna, A Buczaj, M Krzywicka, A Przywara and R Nadulski. Optimization of the ultrasound-assisted extraction of bioactive compounds from cannabis sativa L. leaves and inflorescences using response surface methodology. Applied Sciences 2022; 12(13), 6747.
[9] C Carrera, MJ Aliano-Gonzalez, J Rodriguez-Lopez, M Ferreiro-Gonzalez, F Ojeda-Copete, GF Barbero and M Palma. Optimization of an ultrasound-assisted extraction method for the analysis of major anthocyanin content in erica australis flowers. Molecules 2021; 26(10), 2884.
[10] A Weremfo, F Adulley and M Adarkwah-Yiadom. Simultaneous optimization of microwave-assisted extraction of phenolic compounds and antioxidant activity of avocado (Persea americana Mill.) seeds using response surface methodology. Journal of Analytical Methods in Chemistry 2020; 2020(1), 7541927.
[11] M Kopsel, T Kostka, S Niesen, P Winterhalter and T Esatbeyoglu. Influence of fractionation of polyphenols by membrane chromatography on antioxidant, antimicrobial and proliferation-inhibiting effects of red fruit juices. Food Chemistry 2025; 463(2), 141216.
[12] R Mattioli, A Francioso, L Mosca and P Silva. Anthocyanins: A comprehensive review of their chemical properties and health effects on cardiovascular and neurodegenerative diseases. Molecules 2020; 25(17), 3809.
[13] LS Sunarti. Bacterial contamination in food: Sources, risks, and prevention strategies. International Journal of Pathogen Research 2024; 13(6), 90-100.
[14] F Stoica, OE Constantin, N Stanciuc, I Aprodu, GE Bahrim and G Rapeanu. Optimization of the parameters influencing the antioxidant activity and concentration of anthocyanins extracted from red onion skins using a central composite design. Inventions 2022; 7(4), 89.
[15] U Gromping. An algorithm for blocking regular fractional factorial 2-level designs with clear two-factor interactions. Computational Statistics & Data Analysis 2021; 153, 107059.
[16] CN Njoku and SK Otisi. Application of central composite design with design expert v13 in process optimization, in: Response surface methodology. IntechOpen, London, 2023.
[17] FDO Riswanto, A Desra, RM Sari, V Thomas, A Rohman, S Pramono and S Martono. Employing an R software package rsm for optimizing of genistein, daidzein, and glycitein separation and its application for soy milk analysis by HPLC method. Indonesian Journal of Chemistry 2020; 20(5), 1184-1198.
[18] N Tena and AG Asuero. Up-To-Date analysis of the extraction methods for anthocyanins: Principles of the techniques, optimization, technical progress, and industrial application. Antioxidants 2022; 11(2), 286.
[19] HS Arruda, EK Silva, NMP Araujo, GA Pereira, GM Pastore and MRM Junior. Anthocyanins recovered from agri-food by-products using innovative processes: Trends, challenges, and perspectives for their application in food systems Molecules 2021; 26(9), 2632.
[20] ID Larasati, C Carrera, HN Lioe, T Estiasih, ND Yuliana, Manikharda, HR Daniel Ray, M Palma and W Setyaningsih. Anthocyanin extraction from roselle (Hibiscus sabdariffa L.) calyces: A microwave-assisted approach using Box-Behnken design. Journal of Agriculture and Food Research 2024; 18, 101480.
[21] T Taghavi, H Patel and R Rafie. Extraction solvents affect anthocyanin yield, color, and profile of strawberries. Plants 2023; 12(9), 1833.
[22] GN Mattos, MCPDA Santiago, ACSD Chaves, A Rosenthal, RV Tonon and LMC Cabral. Anthocyanin extraction from jaboticaba skin (Myrciaria cauliflora Berg.) using conventional and non-conventional methods. Foods 2022; 11(6), 885.
[23] R Scogin. Anthocyanins of the genus erythrina (fabaceae). Biochemical Systematics and Ecology 1991; 19(4), 329-332.
[24] J Qiao, L Guo, J Yang, R Gao, Y Ni, J Huo, D Huang, X Sui and Y Zhang. Unveiling the polyphenol profile and bioactive potential of kiwi berry (Actinidia arguta): Antioxidant capacity and enzyme inhibition activities. Food Chemistry 2025; 471, 142839.
[25] KG Kamble and KS Laddha. Extraction, isolation, and characterization of pelargonidin 3,5-o-diglucoside salt from pomegranate flowers. International Journal of Drug Delivery Technology 2023; 13(2), 494-500.
[26] T Iwashina, S Rahayu, K Sugahara, T Mizuno, C Tsutsumi and D Widyatmoko. Acylated pelargonidin and cyanidin 3-sambubiosides from the flowers of Aeschynanthus species and cultivars. Phytochemistry 2021; 192, 112956.
[27] Y Jia, C Wu, A Rivera-Piza, Y Kim, J Lee and S Lee. Mechanism of action of cyanidin 3-o-glucoside in gluconeogenesis and oxidative stress-induced cancer cell senescence. Antioxidants 2022; 11(4), 749.
[28] N Karim, M R I Shishir, Y Li, OY Zineb, J Mo, J Tangpong and W Chen. Pelargonidin-3-o-glucoside encapsulated pectin-chitosan-nanoliposomes recovers palmitic acid-induced hepatocytes injury. Antioxidants 2022; 11(4), 623.
[29] B Enaru, G Drețcanu, TD Pop, A Stanila and Z Diaconeasa. Anthocyanins: Factors affecting their stability and degradation. Antioxidants 2021; 10(12), 1967.
[30] J Flieger, W Flieger, J Baj and R Maciejewski. Antioxidants: Classification, natural sources, activity/capacity measurements, and usefulness for the synthesis of nanoparticles. Materials 2021; 14(15), 4135.
[31] V Deviani, A Hardianto, K Farabi and T Herlina. Flavanones from Erythrina crista-galli twigs and their antioxidant properties determined through in silico and in vitro studies. Molecules 2022; 27(18), 6018.
[32] MT Reetz and G Konig. n-Butanol: An ecologically and economically viable extraction solvent for isolating polar products from aqueous solutions. European Journal of Organic Chemistry 2021; 2021(46), 6224-6228.
[33] D Kim, J Lee and J Yoon. Accurate estimation of the inhibition zone of antibiotics based on laser speckle imaging and multiple random speckle illumination. Computers in Biology and Medicine 2024; 174, 108417.
[34] A Huttner, J Bielicki, MN Clements, N Frimodt-Moller, AE Muller, JP Paccaud and JW Mouton. Oral amoxicillin and amoxicillin–clavulanic acid: Properties, indications and usage. Clinical Microbiology and Infection 2020; 26(7), 871-879.
Supplementary Material
Table Supplementary 1 presents the data obtained from the parameter selection process using a two-level fractional factorial design. The results of the parameter selection experiment are detailed in the TAC column. This data served as a crucial reference for analyzing the main effect plots, providing insights into the influence of various parameters on the total anthocyanin content during the extraction process.
Table S(1) Two level fractional factorial design used in the parameter selection of ultrasound-assisted extraction of anthocyanins from E.crista-galli flowers. The result of the parameter selection experiment are detailed in the TAC column.
No |
Parameters |
TAC (mg/g) |
||||
Extraction Time |
Temperature (°C) |
Solvent concentration (%) |
Solid-liquid ratio |
Number of extraction |
||
1 |
10 |
25 |
40 |
2.5 |
1 |
0.9530 |
2 |
30 |
50 |
40 |
1.25 |
2 |
2.0022 |
3 |
10 |
50 |
80 |
1.25 |
2 |
2.5452 |
4 |
10 |
25 |
40 |
1.25 |
2 |
1.4263 |
5 |
30 |
25 |
40 |
1.25 |
1 |
1.8355 |
6 |
30 |
25 |
80 |
2.5 |
1 |
1.7055 |
7 |
30 |
50 |
40 |
2.5 |
1 |
2.1443 |
8 |
10 |
50 |
40 |
1.25 |
1 |
1.9041 |
9 |
10 |
25 |
80 |
2.5 |
2 |
2.0200 |
10 |
10 |
25 |
80 |
1.25 |
1 |
1.9199 |
11 |
10 |
50 |
40 |
2.5 |
2 |
2.1139 |
12 |
30 |
25 |
40 |
2.5 |
2 |
1.0128 |
13 |
30 |
25 |
80 |
1.25 |
2 |
2.2396 |
14 |
10 |
50 |
80 |
2.5 |
1 |
1.8865 |
15 |
30 |
50 |
80 |
2.5 |
2 |
2.4990 |
16 |
30 |
50 |
80 |
1.25 |
1 |
3.1958 |






